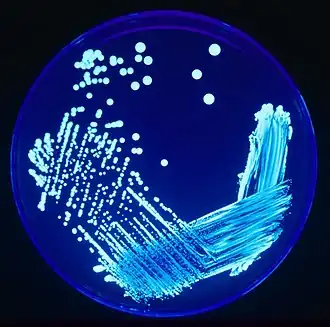

Lidar

La télédétection par laser, lidar ou LIDAR, acronyme de l'expression en langue anglaise « light detection and ranging » ou « laser imaging detection and ranging » (soit en français « détection et estimation de la distance par la lumière » ou « par laser »), est une technique de mesure à distance fondée sur l'analyse des propriétés d'un faisceau de lumière généré artificiellement et renvoyé par la cible vers son émetteur. Si une série de mesures sont effectuées sur une surface, elles permettent d'en dresser une cartographie 3D à distance (à partir d'un avion par exemple).
À la différence du sonar qui utilise des ondes acoustiques et du radar qui emploie des ondes électromagnétiques de plus basse fréquence (ondes radio), le lidar utilise des ondes électromagnétiques proches de la lumière visible (du spectre visible, infrarouge ou ultraviolet). La lumière utilisée par le lidar est presque toujours issue d’un laser, ce qui permet d'avoir une source lumineuse directionnelle, monochromatique, polarisée, de haute amplitude et cohérente.
Le principe de la télémétrie (détermination de la distance d’un objet), qui concerne une grande partie des applications du lidar, requiert généralement l’utilisation d’un laser impulsionnel. La distance est donnée par la mesure du délai (aussi appelé « temps de vol ») entre l’émission d’une impulsion et la détection d’une onde réfléchie, connaissant la vitesse de la lumière. Quand la source laser est entretenue et modulée en fréquence, on parle de lidar FMCW (Frequency Modulated Continuous Wave).
Une autre classe d’applications permet de déterminer la vitesse de l’objet visé en employant un laser à spectre d’émission fin (une fréquence bien déterminée) et en mesurant l'effet Doppler-Fizeau, c'est-à-dire le décalage entre la fréquence de l’onde émise et celle de l'onde reçue en retour.
Beaucoup d’autres paramètres (concentrations de gaz ou de particules spécifiques, densité, température) peuvent être mesurés dans l’atmosphère et les autres milieux diffus si l’on sait isoler l’effet des différentes interactions entre la lumière et la matière le long du faisceau laser.
Résumé des utilisations courantes
Le lidar, instrument de télédétection active[1], trouve des applications en topographie[2] (géomorphologie, altimétrie et bathymétrie), géosciences (risque sismique[3],[4], météorologie[5], physique de l’atmosphère[6]) et sciences de l’environnement (étude de la pollution atmosphérique[7], agronomie & sylviculture[8]), mais aussi dans l’archéologie[9], la prospection éolienne[10], la régulation du trafic aérien[11], le guidage automatique[12] de véhicules terrestres ou spatiaux, ou encore la sécurité routière[13] ou l'industrie militaire[14] (obus Bonus par exemple)[15].
Histoire et dénomination

Peu après leur invention au début des années 1960, les premiers lasers à rubis naturellement impulsionnels de Théodore Maiman sont exploités pour la télémétrie fine à grande distance. Aux États-Unis, Louis Smullin et Giorgio Fiocco du Massachusetts Institute of Technology (MIT) les emploient pour mesurer précisément la distance Terre-Lune en (Project Luna See)[16], alors que Guy Goyer et Robert Watson du National Center for Atmospheric Research (NCAR) les appliquent parallèlement à la mesure de la hauteur des nuages[17]. Ils appellent leur système « radar optique ».
L’utilité et la précision des systèmes lidar deviennent connus du grand public en 1971 lors de la mission Apollo 15[18], qui cartographie la Lune à l’aide d’un altimètre laser. Alors que le mot lidar avait originellement été créé par l’assemblage de « light » et « radar »[19], on considère à partir de cette même époque que leur dénomination est plutôt l’acronyme de « Light Detection And Ranging » ou « Laser Imaging Detection And Ranging », à l’instar de radar ou sonar.
Le terme lidar couvre une très grande variété de systèmes de mesure à distance par laser. Mais ces systèmes sont parfois désignés autrement. On trouve parfois l'acronyme « LADAR » (LAser Detection And Ranging), qui est plutôt utilisé dans le domaine militaire sur des cibles dures ou dans la littérature anglo-saxonne[20]. On trouve également le sigle « ALSM » (Airborne Laser Swath Mapping)[21] pour les applications spécifiques de topographie aéroportée. En français, l'expression « radar laser » est improprement employée par analogie, surtout pour les jumelles de contrôle de vitesse en sécurité routière[13].
Alors que le terme radar est maintenant lexicalisé, l'écriture de son équivalent optique ne fait l’objet d’aucun consensus. Si bien que l’on peut trouver dans différentes publications de référence, parfois même dans le même document, les acronymes « LIDAR », « lidar », « Lidar » ou « LiDaR ».
Le marché du LiDAR automobile devrait croître d'environ 15 fois en cinq ans pour atteindre 4,7 milliards de dollars en 2028[22].
Généralités
De manière générale, le fonctionnement du lidar ressemble à celui du radar (basé sur l'écholocalisation), la différence étant le domaine spectral des ondes électromagnétiques employées. Alors que le radar fonctionne dans le domaine des micro-ondes (fréquences de 1 à 100 GHz, longueurs d’onde millimétriques et centimétriques), le lidar est fondé sur des lasers rayonnant dans le domaine infrarouge, le domaine visible ou le domaine ultraviolet proche (fréquences au-delà de 10 THz, longueurs d’onde de 250 nm à 10 µm). Dans les deux cas, l’onde électromagnétique émise est cohérente et polarisée. Mais dans le domaine spectral visible, elle est beaucoup plus directive et elle peut interagir avec des objets de taille microscopique.

Un lidar est un système opto-électronique composé d’un émetteur laser, d’un récepteur comprenant un collecteur de lumière (télescope ou autre optique) et un photodétecteur qui transforme la lumière en signal électrique, ainsi que d’une chaîne électronique de traitement du signal qui extrait l’information recherchée.

Excepté à courte portée (moins d'un kilomètre), afin de capter un signal suffisamment fort, il est nécessaire d’utiliser :
- un laser de forte puissance moyenne (typiquement supérieure à 100 mW). Ceci doit être concilié avec les exigences de sécurité oculaire dans les applications proches du sol ; la sélection de longueurs d’onde hors du domaine de transparence de la cornée de l’œil (400 à 1 400 nm) ou le balayage du laser aident grandement dans ce sens.
- du côté de la réception, un photodétecteur de sensibilité élevée (photomultiplicateur, photodiode à avalanche), excepté en détection cohérente.
D’autre part, un filtrage de la lumière reçue est indispensable pour s’affranchir de la lumière de l’environnement, qui constitue un fort parasite. On filtre le plus souvent à la fois :
- spatialement, en limitant le champ de vision de l’optique de réception étroitement autour du faisceau laser, à l’aide d’un diaphragme de champ si nécessaire,
- spectralement, à l’aide d’un filtre ne laissant passer qu’une gamme étroite autour de la longueur d’onde du laser ou d’un interféromètre.
Par opposition à cette détection dite « directe », il existe des lidars à détection dite « cohérente » ou « hétérodyne », identique à celle du radar. Dans ce cas, on effectue à la réception un mélange entre l’onde lumineuse reçue et une partie de l’onde émise, qui a été décalée d’une fréquence connue, par exemple par un modulateur acousto-optique (onde dite « d’oscillateur local »). L’interférence de ces deux ondes génère un terme oscillant autour de cette fréquence dans le signal de sortie du photodétecteur, en plus des termes proportionnels à la puissance reçue et à la puissance d’oscillateur local. En filtrant électroniquement le signal dans une bande étroite autour de la fréquence en question, on obtient un signal dit « hétérodyne ».

Avec la puissance et la phase, désignant l'onde reçue et désignant l'oscillateur local, on a l'intensité du signal, dépendant du temps , qui est proportionnelle à :
où est le décalage en fréquence fixe introduit sur l'oscillateur local, est la vitesse radiale de la cible et la longueur d'onde du laser.
Ce procédé a plusieurs intérêts :
- le mélange interférométrique multiplie l’amplitude du signal utile, éliminant le besoin d’un photodétecteur ultra-sensible.
- l’information de phase de l’onde reçue est conservée, alors qu’elle était perdue en détection directe.
- on a ainsi effectué un filtrage spectral extrêmement fin (quelques dizaines de MHz, soit environ 10-4 nm) de la lumière reçue autour de la fréquence centrale, tandis que la condition de cohérence spatiale nécessaire à l’interférence implique un filtrage spatial parfaitement ajusté autour du faisceau émis. Ceci s’apparente à une détection synchrone, méthode éprouvée pour amplifier des signaux de faible amplitude à bande étroite. L’impact de la lumière parasite en lidar cohérent est donc négligeable.
Le lidar cohérent doit faire face à quelques difficultés en contrepartie :
- il requiert une émission laser spectralement fine qui semble a priori incompatible avec la forte puissance nécessaire au lidar.
- un fonctionnement impulsionnel à commutation-Q dans la cavité laser, qui crée des impulsions puissantes mais trop courtes et sans relation de phase, empêche également d’avoir une fréquence bien définie. L’émission doit donc être soit continue, soit contrôlée par un oscillateur maître, soit découpée en impulsions « longues » (plusieurs centaines de nanosecondes) a posteriori puis ré-amplifiée.
- des bruits supplémentaires liés à la turbulence atmosphérique et aux mouvements des cibles (variations du « speckle ») perturbent la mesure en détruisant la cohérence entre les ondes mélangées.
Ce système est directement applicable à la mesure précise de la vitesse de la cible via l’effet Doppler, exactement sur le même principe qu’en radar Doppler. Cet effet provoque un décalage en fréquence de l’onde réfléchie par un objet proportionnellement à sa vitesse en direction de l’observateur, dite vitesse radiale.
Il est difficile de classifier les lidars par principe ou par application ; toutefois, dans la suite, on se propose de les aborder par le type de cible (dure ou diffuse) et le type d’interaction lumière/matière qu’ils observent.
Lidars à cible dure
Lidars télémètres laser à balayage

Le type de lidar le plus simple et le plus répandu demeure le télémètre laser qui calcule directement la distance d’un objet réfléchissant les impulsions laser émises, à partir de la différence de temps entre l’émission d'une impulsion et la réception de l’écho le plus important :
avec la vitesse de la lumière (environ 299 800 km s−1). La précision de cette mesure est inversement proportionnelle à la durée de l’impulsion et augmente avec l’énergie que l’on est parvenu à récupérer sur le photodétecteur du lidar.
On appelle « équation lidar » le bilan de liaison du lidar entre son émission et sa réception, c’est-à-dire l’énergie lumineuse de l’impulsion rétrodiffusée par une cible (supposée lambertienne, c'est-à-dire qui diffuse la lumière uniformément) située à une distance et captée par le lidar[23] :
Dans cette équation :
- représente l’énergie initiale de l’impulsion émise (en J) ;
- est la fonction de recouvrement entre le faisceau émis et le cône de réception du lidar (à valeur entre 0 et 1) ;
- est la transmission (à valeur entre 0 et 1) de l’atmosphère sur l’épaisseur (cf. section lidar atmosphérique) ;
- est la transmission (à valeur entre 0 et 1) et la surface (en m2) du système optique de réception ;
- est l’albédo de la cible (à valeur entre 0 et 1) ;
- est la surface de la cible éclairée par le laser (en m2) ; est la surface totale (en m2) de la tache (« spot ») laser à la distance . Par définition, , d’où pour une cible résolue (cible plus grande que le faisceau) et pour une cible non résolue (cible moins grande que le faisceau).
Application numérique : pour , (propagation sur 1 km en visée horizontale en visibilité moyenne), (optiques et filtres compris), cm2 (optique de 5 cm de diamètre), , cible résolue à une distance km, on a :

Seul un dix-milliardième de l’énergie émise est récupérée à la réception.
Le laser émet de plusieurs dizaines à plusieurs centaines de milliers d’impulsions chaque seconde. En y associant un système de balayage angulaire (« scanner », typiquement à l’aide de miroirs qui dévient l’axe d’émission et de réception d’un angle connu), où en profitant du déplacement connu du porteur du lidar (avion ou satellite), on est capable de localiser les nombreux échos recueillis dans l’espace à trois dimensions. Ceci permet la cartographie en 3D de la surface de la cible du lidar, avec une précision qui peut atteindre quelques centimètres, ou une portée qui peut atteindre plusieurs centaines de kilomètres pour des systèmes spatiaux.
Parmi les très nombreuses applications de ces lidars, on peut citer :
- la reconstitution en 3D d’environnements pour l’architecture, l’urbanisme[24], ou l’exploration spéléologique[25],
- la télémétrie en temps réel pour le guidage automatique de véhicules terrestres[12] (voiture autonome et systèmes d'aide à la conduite) ou spatiaux[26] (rendez-vous orbital, exemple : ATV-5 Georges Lemaître),
- le contrôle de vitesse portatif pour la sécurité routière (jumelles dites à « radar laser »[13]) par télémétrie différentielle : on mesure la variation de la distance de la cible en fonction du temps.
- depuis un avion ou depuis l’orbite, la topographie à haute précision de la Terre[2] (lidar GLAS des satellites ICESat) ou des corps rocheux du système solaire[27] (altimètre MOLA de la sonde martienne Mars Global Surveyor) pour obtenir un modèle numérique de terrain. En archéologie et géomorphologie cette technique aide à détecter des sites enfouis sous la végétation[28] ou l’eau[29] ou bouleversés par la guerre[30],[31]. En , une équipe découvre une cité maya de plus de 2 000 km2 au Guatemala[32]. En foresterie, elle sert à mesurer la hauteur de la canopée ou de la couronne des arbres, ce qui permet d’établir des bilans de couverture végétale, de biomasse ou de risque incendie à de très grandes échelles[2]. Dans ce dernier cas, on note l’utilisation de lidars à large empreinte et à « onde complète » qui extraient les structures de la même manière que les lidars atmosphériques détaillés ci-après.
|

Lidars à détection cohérente pour la mesure de vitesse
De par sa capacité à détecter un décalage en fréquence, le lidar à détection cohérente s'applique directement à la mesure de vitesse d'une cible dure.
Le signal hétérodyne, partie variable du courant en sortie du photodétecteur (en A), s’écrit :
avec le décalage fixe imposé à l’oscillateur local, la vitesse radiale de la cible (projetée vers le lidar), la longueur d’onde émise et donné par l’équation lidar adaptée au cas du lidar cohérent (en supposant l’émission laser continue) :
Dans cette équation, plusieurs termes nouveaux apparaissent (les autres sont explicités dans la sous-section précédente) :
- le rendement hétérodyne (à valeur entre 0 et 1), d’autant meilleur que les fronts d’ondes interférents se ressemblent, et très sensible à la propagation du faisceau,
- , la sensibilité du photodétecteur (en A/W),
- , la puissance émise (en W),
- , la puissance de l’oscillateur local (en W).
Le traitement du signal s’effectue par l’estimation de la fréquence instantanée du signal hétérodyne (opération parfois appelée démodulation, comme en radio), afin de remonter à la vitesse de la cible. Il est à noter que, le lidar ayant une longueur d’onde 10 000 fois plus courte que le radar, la sensibilité en vitesse est d’autant décuplée par rapport aux radar Doppler : 1 MHz de décalage en fréquence correspond approximativement à une vitesse de 1 m/s. Sur des périodes longues, avec une émission laser continue visant une cible dure, on est ainsi capable de sonder des vitesses inférieures au micromètre par seconde.

Applications:
Jusqu’à la fin des années 1990, seuls d’imposants et coûteux lasers à gaz CO2 (infrarouge thermique, µm) avaient les caractéristiques nécessaires de finesse spectrale et de puissance, réservant ce lidar à des applications militaires apparentées au radar[33]. Il s’agit principalement de l’imagerie/télémétrie/vélocimétrie à très grande portée (jusqu’à plusieurs centaines de kilomètres). Il est possible d’aller sonder jusqu’à la forme et les mouvements des satellites et débris spatiaux en orbite terrestre basse, inaccessible aux radars, dont le faisceau est trop divergent.
Par la suite, le développement des lasers fibrés (infrarouge proche, µm), compacts, robustes et moins onéreux, ont ouvert d’autres champs d’application sur cible dure, notamment la vibrométrie laser à grande distance :
- pour la surveillance de la santé mécanique des grandes structures par leurs modes de vibration naturels, qu’il s’agisse d’ouvrages d’art[34], d’une falaise sur le point de se décrocher[35] ou des grands bâtiments d’une ville[4] après un séisme. L’intérêt est de ne pas avoir à s’approcher d’une structure qui peut potentiellement s’effondrer, ou de pouvoir balayer sa surface pour étudier la forme des modes de vibration (par exemple pour repérer des discontinuités causées par des fissures) sans avoir à y déposer des dizaines de capteurs.
- pour la détection de mines terrestres enfouies, révélées par un scan des vibrations du sol soumis à une excitation sonore[36]
- par ailleurs, dans la défense, les lidars vibromètres sont applicables à la détection[37] et à l’identification à grande distance[38] de véhicules terrestres ou aériens par leurs vibrations spécifiques, ou encore à l’espionnage[39]. Ces applications sont toutefois relativement récentes et donc exploratoires.
Lidars à cible diffuse – lidar atmosphérique
Les lidars peuvent effectuer des mesures à travers différents milieux diffus (océan, forêt) outre l’atmosphère, mais nous nous concentrerons sur ce dernier cas, majoritaire et représentatif. Dans l’atmosphère, il s’agit d’analyser les échos lumineux provenant des molécules de l’air ou des particules (aérosols, gouttelettes d’eau ou cristaux de glace) en suspension dans la colonne traversée par le faisceau laser. On étudie l’intensité de la rétrodiffusion ou de l’atténuation de la lumière par ces constituants. Comme dans une échographie, le signal reçu représente une coupe de l’atmosphère.

La difficulté du traitement de ce signal est de séparer les effets d’atténuation de ceux de la rétrodiffusion, ainsi que la contribution respective des particules en suspension et des différentes molécules[40]. C’est un cas exemplaire de problème inverse mal conditionné pour lequel on tente, avec peu d’observables mais un bon modèle mathématique du système physique observé, de remonter aux paramètres caractéristiques du système. Si l’on sait résoudre ce problème, on peut alors accéder à la densité et la concentration de constituants de l’atmosphère, leurs propriétés optiques qui renseignent sur leur nature, mais aussi des paramètres physiques tels que la température ou la vitesse des vents, en fonction de l’altitude. On parle donc « d'inverser » le signal lidar pour le fait de résoudre l'équation qui le décrit.
L’extinction (atténuation) et la rétrodiffusion sont en effet la somme de termes associés aux différentes particules et molécules présents dans l’atmosphère, et dépendent parfois fortement de la longueur d’onde. Chaque terme est le produit de la concentration de l’espèce (en m-3) par la section efficace d’interaction (en m2 pour l’extinction ou m2.sr-1 pour la rétrodiffusion). Ces sections efficaces donnent une idée de l’ordre de grandeur des phénomènes d’interaction.
Importance des interactions lumière-atmosphère en termes de section efficace de rétrodiffusion[41] :
| Interaction | Section efficace de rétrodiffusion | Caractéristiques |
|---|---|---|
| Diffusion de Mie (particules aérosols) | 10-8 - 10-10 cm2sr-1 | Instantanée, élastique (même longueur d’onde) |
| Fluorescence résonnante (ex : espèces métalliques) | 10-13 cm2sr-1 | Instantanée, inélastique (changement de longueur d’onde) |
| Fluorescence (ex : aérosols biologiques) | 10-19 cm2sr-1 | Retardée, inélastique |
| Diffusion Rayleigh (molécules) | 10-27 cm2sr-1 | Instantanée, élastique |
| Diffusion Raman (molécules) | 10-30 cm2sr-1 | Instantanée, inélastique |
Les observations lidar sont principalement représentées sous deux formes :
- Le profil lidar est usuellement la représentation de l'évolution du signal lidar (parfois corrigée de la dépendance en ) ou d'un paramètre dérivé du traitement de ce signal, en abscisse, en fonction de l'altitude , en ordonnée.
- Une série temporelle lidar est une figure en trois dimensions représentant l'évolution du signal lidar (en couleur) en fonction du temps (en abscisse), et de l'altitude (en ordonnée).

On peut classer les lidars atmosphériques suivant le phénomène d’interaction observé.
Lidars à rétrodiffusion (Rayleigh, Mie ou Raman)
Ces lidars sont pour la plupart basés sur des lasers puissants (énergie de plus de 10 mJ par impulsion) émettant entre le proche infrarouge et le proche ultraviolet. La longueur d'onde sera choisie courte si l'on souhaite maximiser l’interaction avec les molécules et petites particules (cas Rayleigh/Raman)[42], ou longue dans le cas contraire (cas Mie). De nos jours, les lasers au néodyme, émettant à 1 064 nm (proche infrarouge), 532 nm (vert) et/ou 355 nm (proche ultraviolet) par doublage ou triplage de fréquence, sont souvent employés.

Dans le cas des lidars « Rayleigh » et/ou « Mie »
On étudie la rétrodiffusion directe des constituants de l’atmosphère à la même longueur d’onde que celle qui a été émise. La diffusion est dite « élastique » : elle se produit sans échange d’énergie entre les photons incidents et le diffuseur rencontré. On distingue la diffusion « Rayleigh » des molécules (la taille du diffuseur est largement inférieure à la longueur d’onde utilisée) de la diffusion « de Mie » des particules aérosols (la taille du diffuseur est du même ordre de grandeur que la longueur d’onde utilisée).
L'« équation lidar » est dans ce cas l’expression de la distribution verticale d’énergie lumineuse rétrodiffusée par une tranche d'atmosphère d'épaisseur et captée par le lidar, en fonction de l’altitude , que l'on cherche le plus souvent à résoudre pour trouver le profil d'extinction ou de rétrodiffusion [42]:
Dans cette équation :
- représente l’énergie initiale des impulsions émises (en J) ;
- est la fonction de recouvrement entre le faisceau laser émis et le cône de réception du lidar à la distance z (à valeur entre 0 et 1) ;
- est la taille de la case distance ou résolution en distance (en m), fixée par Δt qui est le maximum entre la durée de l’impulsion et le temps de réponse de la détection ;
- est la transmission (à valeur entre 0 et 1) et la surface (en m2) du système optique de réception ;
- représente le coefficient d'extinction (ou atténuation, en m-1) à l'altitude et à la longueur d’onde , elle conditionne la transmission de l’atmosphère ;
- représente le coefficient de rétrodiffusion (en m-1.sr-1) à l'altitude et à la longueur d’onde .
Il est à noter que les coefficients d’extinction et de rétrodiffusion sont la somme de contributions particulaire () et moléculaire () évoluant différemment avec la longueur d'onde et l'altitude :
Sachant que l'énergie exacte transmise est rarement connue avec suffisamment de précision, l'équation lidar devient une équation à 5 inconnues au total. Il faut user d'hypothèses simplificatrices pour la résoudre.
- Dans la haute atmosphère (>10 km), il n'y a habituellement pas de particules, et un lidar Rayleigh étudiant uniquement la diffusion des molécules peut remonter, en sachant que , au coefficient d'extinction. Celui-ci étant proportionnel au nombre de molécules, on obtient ainsi des profils de densité de la stratosphère et de la mésosphère. D’autre part, à l’aide d’un interféromètre spécifique placé à la réception (détection dite à « haute résolution spectrale »), il est possible de mesurer le décalage spectral par effet Doppler du spectre de rétrodiffusion des molécules, donnant accès à la vitesse du vent[43].
- Dans la troposphère (<10 km), il faut utiliser des hypothèses simplificatrices (profil de densité moléculaire, albédo des particules), pour réduire le nombre d’inconnues. On remonte ainsi au profil d'extinction des particules (aérosols, gouttelettes ou cristaux dans les nuages) en fonction de l'altitude, qui renseigne sur leur concentration. Différents concepts d’instruments récents (avec une mesure de la dépolarisation de la lumière reçue, ou l’utilisation de plusieurs longueurs d’onde à l’émission) peuvent contribuer à déterminer la nature des particules[44] (« spéciation » : pollution, poussières, cendres, gouttelettes, cristaux) ; par exemple, la phase des nuages (eau liquide : pas de dépolarisation, cristaux de glace : forte dépolarisation).
Applications : De manière générale, les systèmes Rayleigh/Mie sont très divers et conçus spécifiquement en vue d'une application particulière (sol ou aéroporté, particules/molécules, basse ou haute altitude). Beaucoup mettent en œuvre de multiples canaux (Rayleigh, Mie, Raman, dépolarisation…) simultanément pour maximiser le nombre d'observations.
Plusieurs modèles de lidar Rayleigh-Mie sont commercialisés depuis le milieu des années 2000[45] et commencent à équiper des réseaux de surveillance de la basse atmosphère à l'échelle nationale et internationale[46]. Un réseau mondial de lidar à micro-impulsions (émettant des milliers d'impulsions microjoules par seconde, plutôt que les quelques dizaines d'impulsions millijoules par seconde des lidars), MPLNET, a notamment été développé par la NASA[47] :
- étude de la densité, du contenu en eau/glace, de la granulométrie et de la formation des nuages et brouillards[17] ;
- « ceilométrie », mesure de la hauteur d'altitude du plafond nuageux ou « super-ceilométrie » de la couche limite atmosphérique, pour l'aviation civile ou la météorologie[7] ;
- mesure de densité et de température de la moyenne atmosphère (10 à 100 km) terrestre depuis le sol par lidar Rayleigh[48],[49] (mise en évidence d'ondes de gravité dès 1967) ;
- étude de la pollution atmosphérique particulaire[7] (pour la compréhension de ses sources, son effet sur le réchauffement climatique[50], la prévision de la qualité de l’air[51]) et des transports de particules aérosols (pollen, poussières désertiques[52], cendres volcaniques[53]…) depuis le sol ou par satellite (lidar CALIOP sur le satellite CALIPSO, partenariat CNES/NASA) ;
- observation des nuages de glace[54] et poussières[55] dans l’atmosphère de Mars par le lidar de la sonde Phoenix (NASA), inclus à la station météo canadienne MET[56] ;
- mesure de la vitesse du vent par satellite pour l’amélioration des modèles de prévision météorologique (lidar ALADIN sur le satellite ADM-Aeolus[57]), et potentiellement par avion pour la mesure de vitesse air sans sonde Pitot et la détection de turbulence en avant de l’appareil[58].
|
Cas particulier du « lidar vent » : lidar Mie à détection cohérente

Le système communément appelé « lidar vent » est un lidar à diffusion de Mie à détection cohérente hétérodyne, monostatique (une seule optique d'émission et de réception), pour la mesure du champ de vent dans la couche limite atmosphérique : il donne vitesse et direction du vent en fonction de l'altitude, potentiellement jusqu'à 1 ou 2 km, dans la couche proche du sol où des particules (aérosols) réfléchissent son émission. Il s'agit donc d'une version dans le spectre visible du profileur de vents.
L'amplitude du signal peut-être exploitée pour calculer la concentration des aérosols, mais on s'intéresse majoritairement à la phase du signal, dont la dérivée est proportionnelle à la vitesse radiale (projetée sur l'axe du faisceau) du vent Vr de par l'effet Doppler.
S'il n'a accès qu'à la composante radiale de la vitesse du vent, comme figuré ci-contre, une mesure suivant 3 axes ou plus (avec une précision ~cm/s) suffit en théorie à reconstituer, par changement de base, le vecteur vent en trois dimensions (avec une précision meilleure que le m/s). En pratique, on opère souvent un balayage du faisceau incliné suivant un cône autour de la verticale[59], pour mesurer la vitesse suivant des axes multiples.
Applications : Développé dans les années 1980 pour la dynamique atmosphérique par la NOAA à l'aide d'imposants laser CO2 (longueur d'onde 10,6 µm) continus puis des lasers solides Tm/Ho:YAG (2 µm)[60], il se répand plus largement dans les années 2000 grâce à la technologie des lasers à fibre à 1,55 µm[61],[59] dont les composants issus de l'industrie des fibres optiques pour les télécommunications sont fabriqués en grande série. Il est à noter que la résolution en distance est parfois obtenue par défocalisation sur des systèmes fibrés à émission continue[62], le rendement hétérodyne étant beaucoup plus élevé au point de focalisation d'un faisceau convergent.
- Prospection du profil vertical de vent en amont de l'implantation d'un parc éolien pour prévoir sa production énergétique[10].
- Surveillance des tourbillons de sillage, en bout[63] ou sur toute la longueur[64] des pistes de décollage des aéroports, pour régler les intervalles de départ dans les hubs internationaux à fort trafic tels que l'aéroport de Paris-Charles-de-Gaulle[65].
- Cartographie des champs de vent autour des aéroports pour détecter les cisaillements de vent dangereux à l'atterrissage[11],[66].
- Mesure de vitesse air sur hélicoptère[67], les sondes de vitesse classiques étant fréquemment perturbées par le flux d'air du rotor.
|
Dans le cas des lidars « Raman »
On étudie la rétrodiffusion « Raman » de la lumière sur un constituant de l’atmosphère à une longueur d’onde λ différente de celle de l’émission λ0, choisie a priori, et caractéristique d’un composé chimique. Toutefois, ce type de diffusion a typiquement moins d’une chance sur mille de se produire pour chaque photon diffusé, ce qui rend le signal ténu et difficile à isoler.
La diffusion Raman est dite « inélastique », c’est-à-dire qu’il y a échange d’énergie entre le photon et la molécule qui le diffuse ; le photon peut mettre en vibration ou en rotation la molécule au repos, ou absorber l’énergie de vibration ou de rotation d’une molécule excitée. De par la mécanique quantique, les niveaux d’énergie vibro-rotationnels accessibles aux molécules sont quantifiés, et spécifiques à celles-ci. Le spectre de diffusion Raman consiste donc en une série de raies à des longueurs d’onde particulières. C’est une « empreinte digitale » de la molécule. De plus, l’intensité des raies est directement proportionnelle à la concentration des molécules dans l’atmosphère, et leur importance relative dépend de la statistique d'excitation des molécules et peut renseigner sur la température.
Pour l’exploiter, il faut employer à la réception un monochromateur ou plusieurs filtres interférentiels étroits afin de sélectionner ces raies. Un laser de forte puissance est indispensable pour compenser la faiblesse de la diffusion Raman par rapport à la diffusion élastique classique. La mesure de jour en présence de lumière solaire reste difficile.
En contrepartie, l’équation du lidar Raman est simple à résoudre car la rétrodiffusion n’est le fait que d’une seule espèce chimique. Elle s'écrit dans ce cas :
Dans cette équation :
- on distingue la longueur d’onde d’observation de la longueur d’onde émise ;
- représente le coefficient de rétrodiffusion Raman de l'espèce d'intérêt (en m-1.sr-1) à l'altitude entre et . Elle est uniquement due aux molécules ciblées, et est au premier ordre directement proportionnelle à leur concentration.
Cette équation se résout donc facilement si l’on dispose d’un canal de réception « élastique » en parallèle, ou si l’on fait le rapport de la diffusion Raman de deux espèces à des longueurs d'onde proches.
Applications : À longue portée dans l'atmosphère, cette technique relativement nouvelle (années 1990) nécessite des lasers puissants qui sont le plus souvent l’apanage des laboratoires de recherche, mais quelques lidars Raman atmosphériques commerciaux ont récemment été mis sur le marché[68]. On peut envisager à terme un véritable lidar météorologique qui fournirait température et humidité atmosphériques en lieu et place des radiosondes actuellement utilisés en météorologie opérationnelle[5].
- Utilisation de la rétrodiffusion du diazote atmosphérique comme une référence afin de résoudre totalement le problème inverse du lidar Rayleigh-Mie (section précédente) ; on détermine alors précisément la réflectivité (albédo) des particules aérosols et potentiellement leur concentration massique dans la colonne d'air[69],
- Mesure de la concentration de gaz traces spécifiques comme la vapeur d’eau[70] et autres gaz à effet de serre[71],
- Mesure de la température, de la troposphère jusqu’à la mésosphère[72],[73]
À plus courte portée, le lidar Raman serait applicable au contrôle à distance de l’alcoolémie des automobilistes par l’analyse du taux d’alcool dans l’habitacle de la voiture[74] (bien que la réalité de cet appareil ait été remise en cause depuis). Plus vraisemblablement, il a servi à la détection de substances[75],[76] et à la localisation de fuites de gaz[77], toxiques ou dangereux, à distance de sécurité ou dans des installations inaccessibles.

Lidars à fluorescence
La fluorescence est le phénomène par lequel à la suite de l'excitation d'une molécule ou d’un atome par absorption d'un photon, un autre photon est immédiatement ré-émis (exemple de photoluminescence).
Cette ré-émission peut se faire à la même énergie et longueur d'onde (fluorescence résonnante) ou à une énergie inférieure (et longueur d'onde plus grande) lorsqu'il y a eu une légère relaxation non radiative entre-temps (10-10 s). Dans tous les cas, l'excitation a une durée de vie pouvant aller jusqu'à 10-7s et la ré-émission se fait statistiquement avec un léger retard, en suivant une décroissance exponentielle. Il est à noter que contrairement à la diffusion, la ré-émission fluorescente est pratiquement isotrope, c'est-à-dire qu'elle se fait indifféremment dans toutes les directions.
La fluorescence peut évidemment être induite par laser, à distance :
- Par exemple, un composé organique excité par un rayonnement ultraviolet peut réémettre de la lumière visible par fluorescence, sur un spectre étendu. La spectroscopie de fluorescence est une technique courante de vision et d'analyse en chimie organique, biochimie et biologie, car de nombreuses molécules organiques et du domaine du vivant sont fluorescentes. On s'affranchit ainsi aisément de la diffusion simple à la longueur d'onde d'excitation sur les autres constituants du milieu, mais l'énergie réémise étant dispersée sur un plus grand domaine spectral, cela complique sa récupération.
- On peut aussi exploiter la fluorescence résonnante qui existe aux raies d'émission/absorption proches des espèces métalliques de l'atmosphère. Elle a l'avantage de ne pas être étendue spectralement.
Lidars à fluorescence moléculaire (non résonnante)
Un lidar à fluorescence avec une émission dans le domaine ultraviolet et une réception filtrée dans le domaine visible est ainsi capable de détecter la présence et la concentration de molécules organiques fluorochromes, à distance. Cela rend possible une télédétection spécifique du vivant dans l'atmosphère ou dans l'océan.
Par ailleurs, en visant des cibles dures tout en profitant de la résolution temporelle du lidar, on peut détailler la décroissance de la fluorescence avec le temps (la réémission peut durer plusieurs dizaines de nanosecondes), ce qui permet parfois de reconnaître le matériau de la cible (« spectrofluorométrie résolue dans le temps »).
Une première difficulté du lidar à fluorescence moléculaire réside dans la dilution temporelle (plusieurs dizaines de nanosecondes) et spectrale (plusieurs dizaines voire centaines de nm) de l'énergie réémise. Ceci complique fortement l’isolation de la réception du lidar des sources de lumière parasite et limite la portée de ces systèmes. Dans beaucoup de cas visant une espèce particulière, une autre difficulté demeure le réglage précis de la longueur d’onde d’émission laser sur la raie d’absorption de l’espèce étudiée.
D'autre part, si la détection de fluorophores (particules fluorescentes) est aisée, la détermination précise de leur concentration peut devenir assez complexe :
- en premier lieu, la forte absorption de l'espèce visée éteint rapidement l'énergie du laser.
- de plus, à cause du retard de la fluorescence, qui évolue en , avec son temps caractéristique qui peut aller jusqu'à quelques dizaines de nanosecondes, l'excitation et la réémission durent souvent plus longtemps que l'impulsion laser et la résolution temporelle de détection, ce qui brouille spatialement la couche de fluorophores observée avec son environnement.
Typiquement, dans l'atmosphère, pour une couche de concentration (en m-3) dont le plancher se trouve à une altitude , l'équation lidar devient dans le cas d'une fluorescence longue devant la durée d'impulsion et la résolution temporelle[42] :
avec :
- la longueur d'onde d'excitation et la longueur d'onde d'observation ;
- la section efficace de fluorescence à la longueur d'onde d'observation (en m2), donnée par la section d'absorption , le temps de vie radiatif du niveau excité , la répartition spectrale de la fluorescence , et la largeur du filtre à la réception :
- le produit de convolution et un terme de brouillage donné par :
où est la fonction de Heaviside.
Une correction apparentée à une déconvolution est possible pour remonter à la concentration des particules fluorophores. Il faut alors connaître leur coefficient d'extinction massique et le temps caractéristique de fluorescence, ce qui implique de savoir leur nature exacte et d'avoir caractérisé ces propriétés en laboratoire. Dans le cas où la durée de l'impulsion n'est pas négligeable, il faut également connaître la forme de celle-ci.
Applications :
- Dans l'atmosphère, détection à distance des attaques biologiques par dispersion d’aérosols[78].
- Dans l'océan, détection de dégazages, fuites de pétrole[79] et du plancton[80], cartographie de la biodiversité et de la santé des récifs coralliens[81] par un lidar embarqué sur un bateau.
- Sur cible dure, en archéologie, reconnaissance des matériaux de construction par spectroscopie résolue dans le temps, ou mise en évidence de la détérioration biologique d’un site historique[9].
Lidars à fluorescence résonnante
Plusieurs espèces non organiques de la haute atmosphère peuvent aussi être caractérisées par leur spectroscopie de fluorescence dite résonnante, si elles sont excitées à la longueur d'onde d'une raie spectrale d'absorption/émission. On étudie ainsi les confins de la mésosphère où des espèces métalliques telles que le sodium et le fer sont constamment déposées par les météores, ou l'azote ionisé de l’ionosphère, malgré la distance (~100 km)[82].
| Espèce | Na | Fe | K | Ca | N2+ |
|---|---|---|---|---|---|
| Longueur d'onde | 589,1 nm | 372,1 nm | 766,6 / 770,1 nm | 422,8 nm | 393,8 nm |

Le principe physique est le même pour les différentes espèces citées :
- un laser continu asservi à la longueur d'onde voulue par absorption saturée dans une cellule du gaz visé joue le rôle d'oscillateur maître ;
- son émission est décalée par un modulateur acousto-optique de quelques centaines de MHz (Δƒ) alternativement de part et d'autre de la raie pour sonder les atomes de différentes classes de vitesse ;
- un laser impulsionnel injecté par ce flux produit une émission impulsionnelle plus puissante ;
- trois échantillonnages à –Δƒ, 0 et +Δƒ suffisent à reconstituer la fréquence centrale (liée à la vitesse radiale du vent par l'effet Doppler) et l'élargissement (lié à la température) de la raie d'absorption des atomes sondés.
Parce que les impulsions laser sont émises en résonance avec la raie de l'espèce étudiée, la puissance ré-émise est magnifiée d'un facteur 1014 par rapport à la simple diffusion Rayleigh.
En utilisant un laser modeste (impulsions de quelque 10 mJ) et un télescope de taille métrique, un lidar à fluorescence résonnante peut sonder température et vent au-delà de la mésopause (80 km) en quelques minutes. Ces deux mesures sont directes (sans supposition de densité de l'air ou d'équilibre hydrostatique) et simultanées.
Applications :
- Mesure de la densité, de la température et des flux de la haute atmosphère via la spectroscopie de fluorescence des espèces métalliques atmosphérique (de 80 à 100 km environ)[83].
- Étude de l’ionosphère (couche externe de l’atmosphère où apparaisse les aurores boréales) via la fluorescence de l’azote ionisé[84].
Lidars à absorption différentielle : « DIAL »

Un puissant concurrent du lidar à diffusion Raman (très ténue et difficile à observer de jour ou à grande distance) pour la mesure de concentration de gaz traces dans l'atmosphère est le lidar à absorption différentielle (en anglais : Differential Absorption Lidar, DIAL).
Son principe est le suivant :
- on émet des impulsions à deux longueurs d'onde, l'une (dite « ON ») correspondant à une raie spectrale d'absorption d'une espèce moléculaire de l'atmosphère, l'autre (dite « OFF ») très proche mais hors de cette raie d'absorption,
- la lumière à ces deux longueurs d'onde est absorbée très différemment lors de sa propagation, mais a priori réfléchie de manière égale par les constituants de l'atmosphère,
- à la réception, on calcule la différence d'atténuation des signaux ON et OFF, a priori proportionnelle à la concentration de l'espèce recherchée.
En effet, d'après l'équation lidar, on a pour chacune des deux longueurs d'onde ON et OFF :
d'où pour le ratio des énergies :
Or, si est le profil de concentration de l'espèce recherchée (en m-3), sa section efficace d'absorption (en m2), et proche de :
Donc, avec la différence de section efficace d'absorption entre les deux longueurs d'onde et :
et on peut déterminer :
La figure ci-dessus répertorie quelques espèces gazeuses mesurables par cette technique[85], en plaçant leur raies d'absorption sur le spectre UV-Visible-IR, et les types de laser utilisés pour ce faire. Il est à noter que certaines espèces présentes sous forme d'aérosols sont aussi sondables de cette manière[86].
Certains lidar DIAL utilisent la technique de la détection hétérodyne[85] pour s'affranchir totalement du parasite de la lumière ambiante et effectuer des mesures de jour comme de nuit.
Plusieurs difficultés subsistent :
- Il faut disposer d'un laser bi-fréquence accordable en longueur d'onde pour viser le sommet de la raie d'absorption de l'espèce à mesurer (λON), ainsi que son pied (λOFF).
- La précision de cette mesure dépend très fortement de l'absorption cumulée de l'espèce mesurée dans l'atmosphère (épaisseur optique). Il existe une épaisseur optique optimale à atteindre, qui contraint le choix de la raie d'absorption, du laser et donc la conception du système d'émission dans son ensemble, en fonction de la configuration d'observation (depuis le sol, depuis un avion, faible ou forte concentration, gamme d'altitudes d'intérêt…).
- Plus important encore, le phénomène de décalage par la pression (pressure shift) de raies spectrales d'absorption étroites biaise les mesures lidar faites sur de grandes gammes d'altitude, puisqu'au fur et à mesure que la pression décroît en montant dans l'atmosphère, la raie s'écarte de λON et l'absorption diminue. Il faut donc placer λON au flanc de la raie à pression standard, pour qu'elle se rapproche plus du maximum avec l'altitude, et étalonner rigoureusement ce biais pour le soustraire aux mesures.
Applications
- Surveillance de la couche d'ozone stratosphérique[87],[88],[89] (entre 15 et 30 km d'altitude), dont la disparition partielle est l'un des problèmes environnementaux majeurs de la fin du vingtième siècle. L'ozone a été le premier gaz trace de l'atmosphère mesuré par DIAL dans les années 1980 grâce à ses raies d'absorption larges et marquées dans l'ultraviolet.
- Mesure du rapport de mélange en vapeur d'eau atmosphérique (et éventuellement de la température[90]), y compris depuis l'espace[88].
- Mesure des concentrations de gaz à effet de serre tel que le dioxyde de carbone[91] ou le méthane[92]. Le satellite franco-allemand MERLIN[93], en développement, devrait mesurer à partir de 2018 le méthane atmosphérique par la méthode DIAL intégré (la mesure n'est pas résolue en altitude, pour avoir un signal suffisant).
- Mesure de gaz polluants divers dans la troposphère (basse atmosphère) : ozone, dioxyde de soufre, dioxyde d'azote, toluène, éventuellement de manière simultanée par un lidar DIAL à 5 longueurs d'onde[94], système commercialisé par la société allemande Elight jusqu'au début des années 2000.
Lidars « supercontinuum »
À l'aide de lasers à impulsions femtosecondes, ou maximisant les effets non-linéaires dans des fibres optiques ou cristaux spécifiques, il est possible de générer des impulsions lumineuses de spectre très large, couvrant des bandes spectrales de plusieurs micromètres (lumière blanche). On appelle une telle émission « supercontinuum ».
Ceci a amené à envisager un lidar supercontinuum, pour la résolution de l'équation lidar à toutes longueurs d'onde afin d'accéder simultanément à la concentration des espèces gazeuses polluantes[95], aux distributions de taille des aérosols[96] et aux molécules organiques fluorescentes[97]. Le système franco-allemand Téramobile[98] en est une incarnation renommée.
Toutefois, par la dispersion spectrale de leur puissance et les effets dissipatifs de la propagation dans l'atmosphère des faisceaux en régime de forte puissance crête, un problème de bilan de liaison limite la portée et, par conséquent, les applications de ces systèmes. Les derniers travaux à longue portée que l'on peut trouver remontent à la fin des années 2000[99], alors que les travaux récents se concentrent sur la discrimination de gaz à courte portée, sans résolution en distance[100].
Notes et références
- ↑ Cracknell et Hayes 1991.
- 1 2 3 Stoker 2007.
- ↑ (en) T. Paulson, « Lidar shows where earthquake risks are highest », sur SeattlePI, (version du sur Internet Archive).
- 1 2 (en) P. Guéguen et al., « Analysis of reinforced concrete buildings using multipath lidar », dans European Workshop on Structural Health Monitoring, (lire en ligne [PDF]).
- 1 2 (en) E. Brocard et al., « Raman Lidar for Meteorological Observations, RALMO », Atmospheric Measurement Techniques, .
- ↑ (en) G. Baumgarten, « Doppler/Rayleigh/Mie/Raman lidar for wind and temperature measurements in the middle atmosphere up to 80 km », Atmospheric Measurement Techniques, .
- 1 2 3 (en) E. Barrett et O. Ben-Dov, « Application of the Lidar to Air Pollution Measurements », Journal of Applied Meteorology, (lire en ligne).
- ↑ (en) P. Lewis, « Lidar for vegetation applications » [PDF], sur University College London.
- 1 2 (en) V. Raimondi et al., « Fluorescence lidar technique for Cultural Heritage », dans Handbook of the Use of Lasers in Conservation and Conservation Science (lire en ligne).
- 1 2 (en) « Wind power applications »(Archive.org • Wikiwix • Archive.is • Google • Que faire ?), sur Leosphere.
- 1 2 (en) « Windcube 400S-AT : Unambiguous wind shear detection for safe traffic decisions » [PDF], sur Leosphere, (version du sur Internet Archive).
- 1 2 F. Euvrard, « Après Google Street View, bientôt Google Driverless », .
- 1 2 3 « Les radars laser », sur Radars-auto.com.
- ↑ G. Pillet et al., « Wideband Dual-Frequency Lidar-Radar for High-Resolution Ranging, Profilometry and Doppler Measurement », Proceedings of SPIE, vol. 7114, .
- ↑ Nathan Gain, « Nouvelle tranche d'obus BONUS pour la Suède », sur FOB - Forces Operations Blog, (consulté le )
- ↑ Smullin et Fiocco 1962.
- 1 2 Goyer et Watson 1963.
- ↑ J. Abshire, « NASA’s Space Lidar Measurements of Earth and Planetary Surfaces », .
- ↑ J. Ring, « The Laser in Astronomy », New Scientist, .
- ↑ J. Hecht, « Lidar/ladar acronyms », sur LaserFocusWorld.com (version du sur Internet Archive).
- ↑ (en) « Airborne Laser Swath Mapping: Applications to Shoreline Mapping », sur imaging.geocomm.com (version du sur Internet Archive).
- ↑ https://www.forbes.com/sites/sabbirrangwala/2023/07/24/hesai-dominates-the-automotive-lidar-market/?sh=2a88b422119a
- ↑ J. Shaw, Optical Remote Sensing Systems : Lidar & Ladar, Montana State University. [PDF].
- ↑ Y. Kobayashi, Photogrammetry and 3D city modeling, in Digital Architecture and Construction, WITpress (ISBN 1-84564-047-0), 2006
- ↑ M.K. Funk, Empire of Rock : China’s Supercaves, National Geographic, 2014, http://www.nationalgeographic.com/china-caves/
- ↑ Blogueur Julien@ESA, LIRIS: Laser Infra-Red Imaging Sensors demonstrator on ATV-5, 2014.
- ↑ (en) James B. Abshire, Michael D. Smith, Haris Riris et Xiaoli Sun, « Mars Orbital Lidar for Global Atsmopheric and Topographic Measurements », sur International Workshop on Instrumentation for Planetary Missions, (version du sur Internet Archive).
- ↑ McElhanney, McElhanney uses LiDAR to Map Angkor Archaeological Sites, 2014.
- ↑ Successful Subsea Laser Scanner Demonstration by C & C Technologies, 2013.
- ↑ Taborelli, P., Devos, A., Laratte, S., Brenot, J., Bollot, N., Cancès, B., & Desfossés, Y. (2017). « Apport des plans directeurs et de l’outil LiDAR aéroporté pour la caractérisation des impacts morphologiques de la Grande Guerre: exemple de la cote 108 (Berry‑au‑Bac, France) ». Géomorphologie: relief, processus, environnement.
- ↑ de Matos Machado, R., Amat, J. P., Arnaud-Fassetta, G., & Bétard, F. (2016). « Potentialités de l’outil LiDAR pour cartographier les vestiges de la Grande Guerre en milieu intra-forestier (bois des Caures, forêt domaniale de Verdun, Meuse) ». EchoGéo (38)
- ↑ (en) Clynes, « Laser Scans Reveal Maya "Megalopolis" Below Guatemalan Jungle », National Geographic, (lire en ligne, consulté le ).
- ↑ A. Gschwendter & W. Keicher, Development of Coherent Laser Radar at Lincoln Laboratory, LLJ, 2000.
- ↑ T. Miyashita et al., Vibration-based Structural Health Monitoring for Bridges using Laser Doppler Vibrometers and MEMS-based Technologies, Steel Structures, 2008.
- ↑ J.-L. Got et al., Pre-failure behaviour of an unstable limestone cliff from displacement and seismic data, Natural Hazards and Earth System Sciences, 2010.
- ↑ V. Aranchuk et al., Multi-beam laser Doppler vibrometry for landmine detection, Optical Engineering 45, 2006
- ↑ V. Aranchuk et al., Standoff detection of obscured vehicle with laser Doppler vibrometry, Proc. of SPIE 7303, 2009
- ↑ V. Jolivet et al., Feasibility of air target identification using laser radar vibrometry, Proc. of SPIE 5807, 2005
- ↑ Z. Zhu, Integration of Laser Vibrometry with Infrared Video for Multimedia Surveillance Display, City College of New York report for the US Air Force Research Laboratory, 2004.
- ↑ R. Collis & P. Russell, Lidar Measurement of Particles and Gases by Elastic Backscattering and Differential Absorption, in Laser Monitoring of the Atmosphere, 1976.
- ↑ (en) X. Chu, « Lecture on Lidar Remote Sensing » [PDF], sur University of Colorado.
- 1 2 3 Measures 1992.
- ↑ D. Bruneau et al., Wind velocity lidar measurements by use of a Mach-Zender interferometer, comparison with a Fabry-Perot interferometer, Applied Optics 43, 2004
- ↑ S. Burton et al., Aerosol classification using airborne high spectral resolution lidar measurements - methodology and examples, Atmospheric Measurements Techniques 5, 2012
- ↑ (en) « Backscatter LIDAR LB100-D200 », sur Raymetrics.
- ↑ (en) « A European Aerosol Research Lidar Network to Establish an Aerosol Climatology: EARLINET » (consulté le ).
- ↑ (en) « The Micro Pulse Lidar Network », sur Goddard Space Center.
- ↑ (en) E. Silverberg et S. Poultney, « Optical radar back scattering from the mesopause region during July and August 1967 », Technical Report, .
- ↑ (en) L. Sox et al., « Middle Atmosphere Temperature Results from a New, High powered, Large Aperture Rayleigh Lidar », .
- ↑ (en) F. Wagner et al., « Comparison of the radiative impact of aerosols derived from lidar and sunphotometer measurements sous-titre = example of an Indian aerosol plume », Journal of Geophysical research, .
- ↑ (en) Y.-G. Wang et al., « Assimilation of lidar signals : application to aerosol forecasting in the Mediterranean Basin », Atmospheric Physics and Chemistry, vol. 14, .
- ↑ (en) P. Chazette et al., « The mobile Water vapor Aerosol Raman LIdar and its implication in the framework of the HyMeX and ChArMEx programs : application to a dust transport process », Atmospheric Measurement Techniques, vol. 7, (lire en ligne).
- ↑ (en) A. Miffre et al., « Interpretation of Accurate UV Polarization Lidar Measurements : Application to Volcanic Ash Number Concentration Retrieval », Journal of Atmospheric and Oceanic Technology, vol. 29, (lire en ligne).
- ↑ (en) J. Whiteway et al., « Mars Water Ice Clouds and Precipitations », Science, vol. 235, .
- ↑ (en) L. Komguem et al., « Phoenix LIDAR measurements of Mars atmospheric dust », Icarus, vol. 223, .
- ↑ (en) « Meteorological Station (MET) built by the Canadian Space Agency », sur Phoenix Mars Mission.
- ↑ (en) O. Reitebuch, « The Wind Lidar Mission ADM-Aeolus: Recent Science Activities and Status of Instrument Development » [PDF], .
- ↑ (en) N. Cezard et al., « Performance evaluation of a dual fringe-imaging Michelson interferometer for air parameter measurements with a 355nm Rayleigh–Mie lidar », Applied Optics, vol. 48, .
- 1 2 M. Valla, Étude d'un lidar Doppler impulsionnel à laser Erbium fibré pour des mesures de champ de vent dans la couche limite de l'atmosphère, Thèse de doctorat, Télécom Paris, 2005
- ↑ M. Huffaker & M. Hardesty, Remote Sensing of Atmospheric Wind Velocities Using Solid-State and CO2 laser systems, Proc. of IEEE 84, 1996)
- ↑ G. Pearson et al., Analysis of the performance of a coherent pulsed fiber lidar for aerosol backscatter applications, Applied Optics 41, 2002
- ↑ ZephIR lidar, Zephir 300 - Onshore wind lidar.
- ↑ S. M. Hannon & J. A. Thomson, Aircraft wake vortex detection and measurement with pulsed solid-state coherent laser radar, Journal of Modern Optics 41, 1994
- ↑ A. Dolfi-Bouteyre et al., Pulsed 1.5-μm LIDAR for Axial Aircraft Wake Vortex Detection based on High-Brightness Large-Core Fiber Amplifier, IEEE Journal of Selected Topics in Quantum Electronics 15, 2009
- ↑ F. Barbaresco, Radar/Lidar Sensors for Wind & Wake-vortex Monitoring on Airport: Results at Paris CDG.
- ↑ J.-P. Cariou et al., Long Range pulsed coherent lidar for real time wind monitoring in the planetary boundary layer, Coherent Laser Radar Conference, 2012.
- ↑ J.-P Cariou et al, All-fiber 1.5 μm cW coherent laser Anemometer DALHEC. Helicopter flight test Analysis, 13th Cohernet Laser Radar Conference, 2005
- ↑ Lidar Raman Raymetrics.
- ↑ A. Ansmann et al., Combined Raman Elastic-Backscatter LIDAR for Vertical Profiling of Moisture, Aerosol Extinction, Backscatter and LIDAR Ratio, Applied Physics B Vol. 55, 1992
- ↑ S. H. Melfi et al, Observation of Atmospheric Fronts Using Raman Lidar Moisture Measurements, Journal of Applied Meteorology 28, 1989, <0789:OOAFUR>2.0.CO;2
- ↑ D. N. Whiteman, Demonstration Measurements of Water Vapor, Cirrus Clouds, and Carbon Dioxide Using a High-Performance Raman Lidar, Journal of Atmospheric and Oceanic Technology 24, 2007
- ↑ A. Behrendt & J. Reichardt, Atmospheric temperature profiling in the presence of clouds with a pure rotational Raman lidar by use of an interference-filter-based polychromator, Applied Optics 39, 2000
- ↑ M. Radlach et al., Scanning rotational Raman lidar at 355 nm for the measurement of tropospheric temperature fields, Atmospheric Physics and Chemistry 8, 2008.
- ↑ Alcolaser: le radar capable de détecter les vapeurs d'alcool, Technosciences.
- ↑ A. Sedlacek et al., Short-range, Non-contact Detection of Surface Contamination Using Raman Lidar, Proc. of SPIE 4577, 2001.
- ↑ S.K. Sharma et al, Stand-off Raman instrument for detection of bulk organic and inorganic compounds, Proc. of SPIE 6554, 2007
- ↑ H. Ninomiya et al., Development of Remote Sensing Technology for Hydrogen Gas Concentration Measurement Using Raman Scattering Effect, IEEJ Transactions on Electronics, Information and Systems vol. 129, 2009.
- ↑ M. Trost, Detection of biological aerosols using Induced Fluorescence Lidar.
- ↑ R. Karpicz et al., Oil spill fluorosensing lidar for inclined onshore or shipboard operation, Applied Optics 45, 2006
- ↑ S. Palmer et al., Ultraviolet Fluorescence LiDAR (UFL) as a Measurement Tool for Water Quality Parameters in Turbid Lake Conditions, Remote Sensing 5, 2013
- ↑ M. Sasano et al., Development of boat-based fluorescence imaging lidar for coral monitoring, Proceedings of the 12th International Coral Reef Symposium, 2012.
- ↑ Chu et al. 2012.
- ↑ Mégie et Blamont 1977.
- ↑ (en) R. Garner et P. Dao, « Molecular nitrogen fluorescence lidar for remote sensing of the auroral ionosphere », Journal of Geophysical Research, vol. 100, .
- 1 2 F. Gibert, « Lidar à absorption différentielle » [PDF], sur Centre national de recherches météorologiques, .
- ↑ (en) K. Douglass, « Progress and promise in DIAL lidar », sur NIST, .
- ↑ (en) « NASA Langley DIAL factsheet », sur NASA, .
- 1 2 (en) E. V. Browell et al., « Differential absorption lidar (DIAL) measurements from air and space », Applied Physics, vol. B 67, .
- ↑ (en) J. A. Seabrook et al., « LIDAR measurements of Arctic boundary layer ozone depletion events over the frozen Arctic Ocean », Journal of Geophysical Research, vol. Atmospheres 117, .
- ↑ (en) V. Wulfmeyer et J. Bösenberg, « Ground-based differential absorption lidar for water-vapor profiling : assessment of accuracy, resolution, and meteorological applications », Applied Optics, vol. 37, .
- ↑ (en) W. Grant et al., « CO2 DIAL measurements of water vapor », Applied Optics, vol. 26, .
- ↑ (en) T. Refaat, « Performance evaluation of a 1.6-µm methane DIAL system from ground, aircraft and UAV platforms », Optics Express, vol. 21, .
- ↑ (en) « MERLIN (Methane Remote Sensing Lidar Mission) Minisatellite », sur eoPortal.
- ↑ (en) D. Weidauer et al., « Ozone, VOC, NO2, and Aerosol Monitoring in Urban and Industrial Areas Using a Mobile DIAL System », dans Advances in Atmospheric Remote Sensing with Lidar, .
- ↑ (en) P. Rairoux et al., « Remote sensing of the atmosphere using ultrashort laser pulses », Applied Physics, vol. B 71, (lire en ligne [PDF]).
- ↑ (en) G. Méjean et al., « Towards a supercontinuum-based infrared lidar », Applied Physics, vol. B 77, (lire en ligne [PDF]).
- ↑ (en) G. Méjean et al., « Remote detection and identification of biological aerosols using a femtosecond terawatt lidar system », Applied Physics, vol. B 78, (lire en ligne [PDF]).
- ↑ « Projet Teramobile ».
- ↑ (en) D. Brown et al., « Supercontinuum lidar applications for measurements of atmospheric constituents », dans Laser Radar Technology and Applications, coll. « Proc. SPIE » (no 6950), .
- ↑ Alexandre Dobroc, Étude et réalisation de dispositifs optiques à large couverture spectrale pour la détection multi-gaz à distance (thèse de doctorat en physique), École Polytechnique, (lire en ligne [PDF]).
Voir aussi
Bibliographie
Travaux historiques
- [Smullin et Fiocco 1962] (en) L. D. Smullin et G. Fiocco, « Project Luna See : A lunar laser ranging experiment », Institute of Electrical and Electronics Engineers Proceedings, vol. 50, .
- [Goyer et Watson 1963] (en) G. Goyer et R. Watson, « The Laser and its Application to Meteorology », Bulletin of the American Meteorological Society, vol. 44, .
- [Mégie et Blamont 1977] (en) G. Mégie et J. E. Blamont, « Laser sounding of atmospheric sodium : interpretation in terms of global atmospheric parameters », Planetary and Space Sciences, vol. 25, . Premier lidar atmosphérique en France.
Ouvrages de référence
- [Measures 1992] (en) R. M. Measures, Laser Remote Sensing : Fundamentals and Applications, Malabar FL, Krieger Pub. Co., , 510 p. (ISBN 0-89464-619-2).
- [Cracknell et Hayes 1991] (en) A. P. Cracknell et L. Hayes, Introduction to Remote Sensing, Londres, Taylor and Francis Ed., (ISBN 978-0-415-33579-9).
- [Weitkamp 2005] (en) C. Weitkamp, Lidar : Range-Resolved Optical Remote Sensing of the Atmosphere, Springer, , 455 p. (ISBN 978-0-387-40075-4, lire en ligne).
Articles connexes
- Radar, Sonar, Sodar
- Laser, Liste des différents types de laser, Supercontinuum
- Lasergrammétrie
- Effet Doppler
- Télédétection
- Télémètre laser, Vibromètre laser, Scanner tridimensionnel, assimilables à des lidars de courte portée.
- Techniques laser à courte portée à ne pas confondre avec le lidar : LIBS (spectroscopie sur plasma induit par laser), CARS (spectroscopie Raman anti-Stockes cohérente), Vélocimétrie laser.
- Le principe du lidar appliqué au contrôle de fibres optiques : la technique de l'Optical Time Domain Reflectometer.
- CALIOP, lidar franco-américain sur le satellite CALIPSO, en orbite depuis , et ALADIN, lidar français sur le satellite ADM-Aeolus.
Liens externes
- [Stoker 2007] (en) J. Stoker, « Introduction to Lidar, USGS »(Archive.org • Wikiwix • Archive.is • Google • Que faire ?) [PDF], (consulté le ). Introduction au lidar aéroporté
- [Chu et al. 2012] (en) X. Chu et al., « Lidar Measurements of Winds in the Upper Atmosphere »(Archive.org • Wikiwix • Archive.is • Google • Que faire ?) [PDF], sur University of Colorado at Boulder, (consulté le ). Lidar à fluorescence résonnante
- P. Flamant, « Fondamentaux lidar »(Archive.org • Wikiwix • Archive.is • Google • Que faire ?) [PDF], sur École polytechnique, (consulté le ).
- J. Pelon, « Les missions spatiales lidar »(Archive.org • Wikiwix • Archive.is • Google • Que faire ?) [PDF], sur Centre national de recherches météorologiques, (consulté le ).
- Applications: Les aspirateurs robots : Honiture Q6,Dreame w10, Lubluelu A9
- Vulgarisation : [vidéo] « Le LIDAR : d'APOLLO 15 à la voiture autonome - Spatialiste #22 », sur YouTube
- Portail de la physique
- Portail de l’électricité et de l’électronique
- Portail de l’information géographique
- Portail de l’optique
- Portail de la météorologie


_Globe.jpg)






